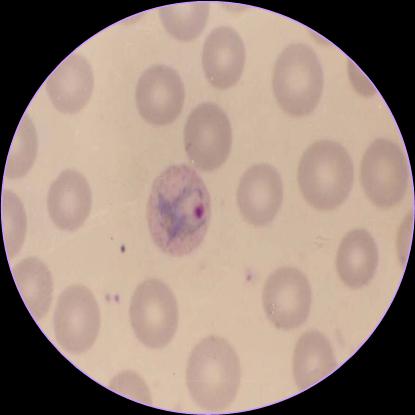
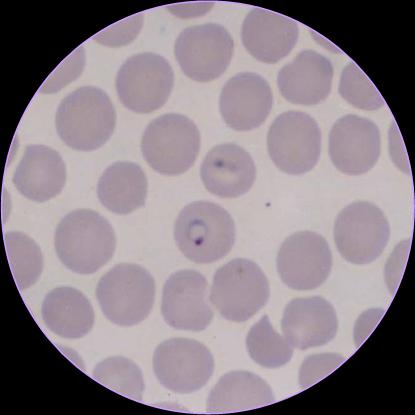
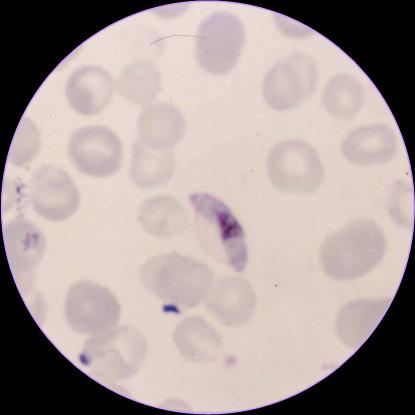
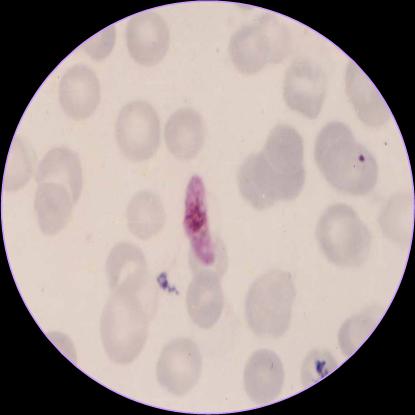

医学原虫
上一节
下一节
P.V成熟裂殖体

P.V雌(大)配子体

P.V大滋养体

P.V环状体

P.V未成熟裂殖体

P.V雄(小)配子体

Pf大(雌)配子体

Pf小(雄)配子体

Pf小滋养体

结肠内阿米巴包囊

蓝氏贾第鞭毛虫包囊

蓝氏贾第鞭毛虫滋养体

溶组织内阿米巴包囊

溶组织内阿米巴大滋养体

阴道毛滴虫

目录
P.V成熟裂殖体

P.V雌(大)配子体

P.V大滋养体
P.V环状体
P.V未成熟裂殖体

P.V雄(小)配子体

Pf大(雌)配子体
Pf小(雄)配子体
Pf小滋养体

结肠内阿米巴包囊

蓝氏贾第鞭毛虫包囊

蓝氏贾第鞭毛虫滋养体

溶组织内阿米巴包囊

溶组织内阿米巴大滋养体

阴道毛滴虫
